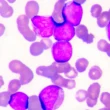

العيش مع مرض السكر يتطلب فهماً عميقاً والتزاماً يومياً للحفاظ على الصحة والوقاية من المضاعفات. يواجه الكثيرون تحديات في كيفية التعامل مع مرض السكر بفاعلية، سواء كان ذلك في تنظيم الوجبات، ممارسة النشاط البدني، أو حتى إدارة التوتر. هذا المقال هو دليلك الشامل لتعلم الطرق السليمة لإدارة مرض السكر، وكيفية التصرف الصحيح عند ارتفاع أو انخفاض مستويات السكر في الدم لتعيش حياة صحية ونشطة.
جدول المحتويات
- كيفية التعامل مع مرض السكر بشكل عام
- التعامل مع ارتفاع سكر الدم (فرط السكر)
- التعامل مع انخفاض سكر الدم (نقص السكر)
- الخلاصة
كيفية التعامل مع مرض السكر بشكل عام
يتطلب الحفاظ على مستوى السكر الطبيعي في الدم التزاماً يومياً وفهماً للعوامل المؤثرة. تتضمن الإدارة الفعالة لمرض السكر مجموعة من الخطوات الأساسية التي تساعدك على التحكم في حالتك الصحية والوقاية من المضاعفات المحتملة. إليك أهم هذه الخطوات:
التغذية الصحية: مفتاح إدارة السكر
يلعب الطعام دوراً محورياً في مستويات سكر الدم. يجب عليك تعلم كيفية حساب كمية الكربوهيدرات في وجباتك، حيث إنها تؤثر بشكل مباشر على السكر. احرص على تناول وجبات متوازنة غنية بالخضروات، الفواكه، البروتينات، والدهون الصحية.
استشر طبيبك بخصوص توقيت تناول الأدوية وعلاقتها بوجبات الطعام. تجنب المحليات الصناعية والأطعمة المصنعة التي ترفع السكر بسرعة وتفتقر إلى القيمة الغذائية.
ممارسة النشاط البدني بانتظام
تُعد الرياضة طريقة رائعة لخفض مستوى السكر في الدم وتحسين حساسية الجسم للأنسولين. خصص 150 دقيقة على الأقل أسبوعياً للنشاط البدني، والذي يمكن تقسيمه إلى نصف ساعة يومياً.
لا تحتاج إلى عضوية في نادٍ رياضي؛ فالمشي السريع، الركض الخفيف، أو ركوب الدراجة كلها خيارات ممتازة ومتاحة للجميع لتبقى نشيطاً.
إدارة التوتر والضغط النفسي
يؤثر التوتر بشكل سلبي على مستويات سكر الدم، حيث يزيد من إفراز الهرمونات التي تقلل من حساسية الخلايا للأنسولين. كما يقلل التوتر من طاقتك ويؤثر على التزامك بنظامك الغذائي وممارسة الرياضة وتناول الأدوية.
ابحث عن طرق فعالة لإدارة توترك مثل التأمل، تمارين التنفس العميق، قضاء الوقت مع أحبائك، أو ممارسة هواياتك المفضلة.
المراقبة الذاتية لمستوى سكر الدم
تُعد مراقبة مستوى السكر بنفسك أمراً ضرورياً لإدارة مرض السكر بفاعلية. يشمل ذلك إجراء فحص السكر التراكمي (HbA1c) بانتظام وفقاً لتوجيهات طبيبك، بالإضافة إلى القياس اليومي لمستوى السكر في المنزل.
يختلف عدد مرات القياس اليومي حسب نوع العلاج الذي تتبعه. يساعدك تسجيل قراءاتك على فهم كيفية استجابة جسمك للعلاج والوجبات والنشاط البدني.
الحفاظ على وزن صحي ومثالي
يُعد الحفاظ على وزن صحي أو خسارة الوزن الزائد خطوة حاسمة لمرضى السكر، خاصة النوع الثاني. أظهرت الدراسات أن فقدان الوزن يمكن أن يحسن بشكل ملحوظ من نتائج فحص السكر التراكمي.
تحدث مع طبيبك أو أخصائي التغذية لوضع خطة صحية للوصول إلى وزنك المثالي والحفاظ عليه.
الإقلاع عن التدخين: خطوة حاسمة
يزيد التدخين من خطر الإصابة بمضاعفات مرض السكري وأمراض القلب بشكل كبير، كما يقلل من قدرتك على التحكم بمستويات السكر في الدم. الإقلاع عن التدخين هو أحد أهم القرارات التي يمكنك اتخاذها لتحسين صحتك العامة.
اطلب الدعم والمشورة من طبيبك لمساعدتك في هذه الخطوة الهامة.
الالتزام بخطة العلاج الدوائي
إذا وصف لك الطبيب أدوية لمرض السكر، فمن الضروري جداً الالتزام بتناولها في مواعيدها المحددة وبالجرعات الموصى بها. يساعد هذا الالتزام على تحقيق أفضل النتائج الممكنة والتقليل من مخاطر المضاعفات.
لا تقم بتغيير جرعات أدويتك أو التوقف عن تناولها دون استشارة الطبيب المشرف على حالتك.
التعامل مع ارتفاع سكر الدم (فرط السكر)
يمكن أن يحدث ارتفاع السكر في الدم بسبب عوامل مثل عدم الالتزام بالأدوية، تناول كميات كبيرة من الكربوهيدرات، أو قلة النشاط البدني، أو الإجهاد. عند مواجهة ارتفاع مستمر في سكر الدم، يجب عليك التصرف بفاعلية للسيطرة عليه.
- كن أكثر نشاطاً: إذا لم يكن هناك وجود للكيتونات في البول، فإن زيادة النشاط البدني يمكن أن تساعد في خفض مستوى السكر. استشر طبيبك قبل البدء بأي تمرين إذا كنت قلقاً بشأن الكيتونات.
- التزام بالحمية: راجع نظامك الغذائي مع أخصائي التغذية أو الطبيب للتأكد من أنك تتبع حمية مناسبة لمرضى السكر.
- مراجعة الأدوية: قد يرى طبيبك ضرورة لتعديل جرعات أدويتك الحالية أو إضافة دواء جديد. التزم تماماً بالجرعات الجديدة والمواعيد المحددة.
- ضبط الأنسولين: إذا كنت تستخدم الأنسولين، فتواصل مع طبيبك لتحديد الجرعة الإضافية اللازمة لتصحيح مستوى السكر المرتفع.
التعامل مع انخفاض سكر الدم (نقص السكر)
يُعرف انخفاض السكر في الدم (نقص السكر) بأنه حالة خطيرة قد تسبب أعراضاً مثل الرعشة، التعرق الشديد، الجوع المفاجئ، والدوخة. إذا شعرت بهذه الأعراض وقمت بقياس السكر ووجدته أقل من 70 ملغم/ ديسيلتر، تصرف فوراً باستخدام قاعدة “15-15”:
- تناول 15 جراماً من الكربوهيدرات سريعة المفعول: يمكنك تحقيق ذلك بتناول أحد الخيارات التالية:
- 4 ملاعق صغيرة من السكر.
- نصف كوب (114 مل) من عصير الفواكه.
- نصف كوب (114 مل) من الصودا العادية (تجنب الأنواع الخاصة بتخفيف الوزن).
- 4 قطع من الحلوى الصلبة.
- انتظر 15 دقيقة: أعد قياس مستوى السكر في الدم.
- كرر إذا لزم الأمر: إذا ظل مستوى السكر منخفضاً، كرر الخطوات السابقة حتى يعود السكر إلى المستوى الطبيعي.
بعد عودة السكر لمستواه الطبيعي، تناول وجبة خفيفة تحتوي على كربوهيدرات وبروتين لمنع عودته للانخفاض مجدداً، مثل شطيرة خبز أسمر مع جبن.
الخلاصة
إن كيفية التعامل مع مرض السكر بفاعلية هي رحلة تتطلب التزاماً ومعرفة مستمرة. من خلال تبني نمط حياة صحي، ومراقبة مستويات السكر بانتظام، والالتزام بخطة العلاج، يمكنك العيش حياة كاملة ونشطة. تذكر دائماً أن فريق الرعاية الصحية الخاص بك هو شريكك الأساسي في هذه الرحلة، ولا تتردد في طلب المشورة والدعم عند الحاجة.